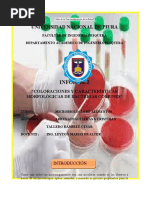

0% encontró este documento útil (0 votos)
1K vistas20 páginasInforme de Laboratorio 1 COLORACION GRAM TERMINADO
Este documento presenta el informe de laboratorio sobre la tinción de Gram. Explica que la tinción de Gram es una técnica utilizada para diferenciar bacterias en Gram positivas y Gram negativas basada en su estructura de pared celular. Describe los objetivos de reconocer las diferencias estructurales y clasificar bacterias según su coloración con Gram. Además, presenta la teoría sobre cómo la tinción funciona y las diferencias en la pared celular que determinan si una bacteria es Gram positiva o negativa. Finalmente, enumera los materiales necesarios
Cargado por
Jony SotoDerechos de autor
© © All Rights Reserved
Nos tomamos en serio los derechos de los contenidos. Si sospechas que se trata de tu contenido, reclámalo aquí.
Formatos disponibles
Descarga como DOCX, PDF, TXT o lee en línea desde Scribd
0% encontró este documento útil (0 votos)
1K vistas20 páginasInforme de Laboratorio 1 COLORACION GRAM TERMINADO
Este documento presenta el informe de laboratorio sobre la tinción de Gram. Explica que la tinción de Gram es una técnica utilizada para diferenciar bacterias en Gram positivas y Gram negativas basada en su estructura de pared celular. Describe los objetivos de reconocer las diferencias estructurales y clasificar bacterias según su coloración con Gram. Además, presenta la teoría sobre cómo la tinción funciona y las diferencias en la pared celular que determinan si una bacteria es Gram positiva o negativa. Finalmente, enumera los materiales necesarios
Cargado por
Jony SotoDerechos de autor
© © All Rights Reserved
Nos tomamos en serio los derechos de los contenidos. Si sospechas que se trata de tu contenido, reclámalo aquí.
Formatos disponibles
Descarga como DOCX, PDF, TXT o lee en línea desde Scribd